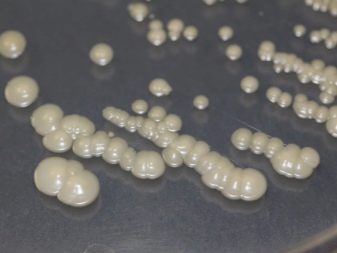

Favorite pearls are the favorite stone of many connoisseurs of beauty. It is often used in the manufacture of beautiful jewelry. However, it is not always the stone, issued for natural pearls, turns out to be real. On sale there are many fakes, which at first glance is not so easy to identify. Today we will look at how we can distinguish natural pearls from a well-made copy of it.
What you need to know about natural pearls?
Jewelry made from freshwater pearls are luxury and are expensive. This beautiful stone is subdivided into several varieties., each of which has its own characteristics.
Let's get acquainted with them.
- Sea pearls. This stone of marvelous beauty has an ideal rounded shape and is notable for its attractive luster The life cycle of this beauty is on average 10 years. In the sink stone matures over several years. In one shell can be formed from 1 to 3 pearls.
After a short period of time, sea stones begin to slowly lose their brightness and characteristic luster, as the thin mother-of-pearl layer begins to wear out. The color of such pearls is not only white, but also brighter, and even coarse black.
- Freshwater. Pearls of this type are mined from mollusks that live in rivers and lakes. The number of mother-of-pearl stones in one shell can vary from 12 to 16 pieces. They have a dimmer color, their brilliance is not evident, being muffled. The shape of such a pearl can vary greatly.
There are not only rounded, but also oval variants (they are the most common). These stones are resistant to abrasion, because their nacreous layer is deeper and denser. The layer hue is most often milky. Freshwater pearls are never pink or black.
Since the cost of wild pearls is very significant, a natural cultured stone can serve as an alternative.
The formation of wild stones and the cultivation of their analogs are identical to each other. The only difference is that in one case, the appearance of pearls is provoked by alien individuals from the side, and in the other - by humans.
Options fakes
There are several types of fake stones, made by man and given out for a natural wild product.
Artificial stones are often given for natural. If they are made well, it can be very difficult to distinguish them from wild pearls.
Consider several types of artificial pearls, which are most often used as an imitation of a real stone.
So, “Majorica” is the most famous pearl of artificial origin. This type of stone is rightfully recognized as one of the most spectacular and beautiful. This type is very common.
Otherwise it is called "orchid". Make this beauty on the famous island of Majorca for 120 years. The basis of these stones are balls of porcelain or alabaster. Finished beads are hard enough to distinguish from wild pearls.
Also exist Parisian and Venetian types of pearls. Technologies of their production have been developed for a long time. Make french pebbles from blown glass filled with wax or paraffin of the desired color.
Venetian technology has much in common with the method of making beautiful French pearls, so it is relevant and in demand no less. With this method, the balls are also made of blown glass, but with the introduction of wax and special pearl dust.
The most modern copies of natural pearls are stones made by special shell technology. It was developed in the USA, but managed to become famous in all countries of the world. In accordance with it, lacquer layers consisting of polymer elements and mica, titanium oxide and carbonic lead are applied on the pearl bead.
Beautiful and natural looking roman pearls. It is made of hollow glass parts filled with paraffin.
The method of creating such stones was invented in the Middle Ages, but at that time the method of work was more crude. A little later, special fish scale essences began to be applied to cover the basics.
Thanks to this technique, the type of artificial pearls becomes more attractive and noble. Properly made Roman stones are not easy to distinguish from natural pearls.
On sale can be found and imitation of pearls from plastic. Such parts are most often used to complement various items of jewelry.
They are frankly cheap, as they look. To confuse natural pearls with plastic is not difficult.
Authentication Methods
It is possible to distinguish artificially derived stone from natural stone independently. This can be done at home without spending extra and wasting time. Consider what ways to determine the naturalness of pearls exist.
Visuals
First of all, when testing the quality of a stone, people rely on visual methods of verification. During these procedures, it is required to evaluate some appearance factors related to the stone.
We must look to shape, surface finish and weight of the pearl product.
The form of natural stone in most cases turns out to be a bit irregular. Ideal and flawless it should not be.
Pearls are slightly elongated, elliptical, ovoid, and even pear-shaped. As for perfectly rounded stones, they are not as common as it seems to many people. Mostly they complement the rings and earrings. Most often these are cultivated gems.
Perfect-shaped wild pearls are very expensive. It is often auctioned, as are luxury large diamonds.
If you are offered beautiful catchy beads consisting only of regular spherical pearls, which cost less than a few thousand rubles, this will mean that you have a fake decoration. Even cultured perfectly round pearls will not be cheap.
The shade of the beads can be snow white, pink, yellowish, silver, green, blue, purple or black.
The further the colors are from white, the brighter the product color will be, and the more expensive it will cost.
As for the surface of pearls, then a natural stone will always have a small amount of uneven and slightly rough.
In addition, there will be spots marked with shine. For a mineral of natural origin is characterized by a heterogeneous color. By this factor, it is also possible to determine the naturalness of the stone - the color of a fake pearl will always be uniform.
If there is a re-drilling on the bead, then you should look under the magnifying glass at the edges that are located near the hole made. If there is a darker nucleolus, then the stone is a fake.
In addition, near the hole you can see small scratches on the paint or smudges. You should use a magnifying glass to distinguish the spots that are on the dye.
Pearls that have been radioactively treated acquire an interesting dark ash or even dense black color.
In a similar way, imitation of a spectacular black sea pearl, which is one of the most valuable, is produced. In this way, cheaper pearls are made from cheap river stones.
Should pay attention to weight pearls. Likewise, it will be easiest to check things, for example, beads, necklaces or bracelets. They should not be the lightest and have an impressive mass, because pearls are a rather heavy mineral. The more stones there are on the thread, the heavier the decoration will be in general.
Often in stores sell plastic beads under the guise of pearl.
If you take in the hands of plastic jewelry, they will be very light, especially in comparison with natural minerals. Glass beads will also have a much lighter weight.
Mechanical
To check the real stone or fake, this method is used very often. It is based on the mechanical properties of pearls. This is a fairly dense substance, the level of hardness which reaches 4 units of moss. Low hardness indicators allow you to check the stone "on the tooth."
If you bite it neatly, you will feel on the tongue and teeth a powder of small fraction, a creak will be heard. This is a great method to recognize a natural mineral. However, it may not work if you have the “Majorica” described above.
The main disadvantage of this method is that the experiment can be carried out exclusively at home, already on the purchased thing. In the jewelry store, you will not be allowed to carry out such manipulations.
There is another mechanical method - friction. Beads need to gently rub each other. As a result, some pearl powder will appear.
But it is necessary to take into account that this option will not help if you have “Majorica” in front of you. This is explained by the fact that such stones have coatings with true mother-of-pearl, even if they are of non-natural origin.
You can check the pearls on strength. The bead will need to be dropped on a hard surface. If the material is natural, not very large traces of impact will remain on it, for example, dents or scratches. The observed damage on the natural stone can be easily smoothed with a finger.
On the same glass or plastic parts no defects, most likely, will not remain. Besides, plastic elements will bounce off a hard surface like a ball. With a pearl this can not be.
Chemical-physical
These methods of checking the origin of pearls are based on certain chemical properties of the mineral. For example, these pearls have low thermal conductivity - they warm very slowly, like most other natural stones.
Pearl necklaces or necklaces will be felt cold on the skin. If the decoration is made of glass or plastic, then it will quickly heat up, in contact with the human body.
If the authenticity of the chosen things arise even the slightest doubt, You can negotiate with a familiar radiologist. He will allow to place an accessory in the x-ray machine. This method can be carried out only in relation to one bead, and not all at once, because under irradiation conditions these elements can turn black. The taken picture will give the chance to understand what the internal structure of material is: the number of layers, the level of density, the presence of the nucleus and other features.
If you put a stone in a fire, then in a couple of minutes no major changes should happen to it. If the bead is made of plastic, then it will quickly melt. Details of glass under the influence of fire burst.
To determine the authenticity of pearls will help vinegar. It is necessary to put a stone in it and preferably only one, as is the case with X-rays, since vinegar can quickly dissolve all the beads. If before you "Mayorika", after placing it in vinegar from it will remain only a simple core of glass. With imitation of plastic or glass there will be no changes.
Formal
In this case, it is not the methods of testing stones that are meant. Formal methods you insure yourself against fraud by the seller.
The main factor to which it will be necessary to pay attention - this cost of goods. Natural product will certainly be expensive. Even those minerals that are not particularly valuable will not cost less than a few thousand rubles. This is very important to consider. If you are offered something cheaper, then, most likely, it will be a product of plastic or glass.
Pearl jewelry is recommended to buy in reputable jewelry stores with a good reputation.
When buying such an accessory, it is advisable to request quality certificate and get acquainted with it in detail. So you protect yourself from buying a fake item.
To find out whether the stone is natural in front of you, you can turn to experts. True, this can be done with an already purchased accessory. So you can be sure that you have bought a natural thing, or you find out that it is not.
What to look for when buying?
If you decide to purchase a pearl jewelry in the jewelry salon, then when choosing it you will need to determine the naturalness of the stone. The following parameters should be considered to choose a quality accessory.
- Pay attention to the cost. As mentioned above, natural stone will not be too cheap.
- Hold the jewelry in your hands. If it seems too easy for you, then you should not take it - it is fake. This pearl has an impressive weight. With plastic or glass in matters of weight it is difficult to confuse.
- Take a closer look at the shape of the pearls. They must have different shapes and sizes. Absolutely identical stones in a necklace or bracelet can not be, if the accessories are made from natural mineral.
- Pay attention to the glitter decorations. Natural stone beautifully and brilliantly. If the pearls are faded, then you have a fake.
- Examine the surface of the selected product. Natural stones will be rough.
- Hold the thing in your hands. If it immediately warms up and becomes warm, it will mean that an artificial mineral was used in its manufacture. Real pearl jewelry will be just cold.
- Be sure to request a quality certificate for your chosen product., even if the thing looks perfect and there is no doubt about its naturalness.
Specialist recommendations on what to look for when choosing pearl products can be found in the following video.